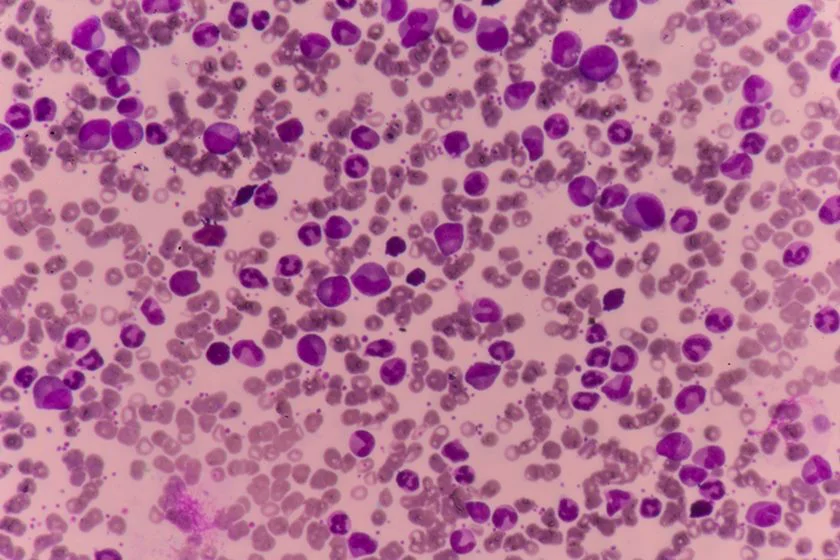

Dormir pouco pode aumentar risco de coágulos sanguíneos, aponta estudo
De acordo com a pesquisa, voluntários que dormiam menos de 5 horas por noite apresentaram risco aumentado para a formação de coágulos Por Yasmin Gurgel,


De acordo com a pesquisa, voluntários que dormiam menos de 5 horas por noite apresentaram risco aumentado para a formação de coágulos Por Yasmin Gurgel,

A Polícia Civil localizou nesta terça-feira (14.03) uma rinha de galo, em Alto Araguaia e uma pessoa foi conduzida por crime ambiental. A Delegacia do

Entidades pediram que a ONU questione o Brasil sobre a coleta de dados de cidadãos durante a pandemia e o uso de programas de espionagem

Anúncio foi feito pela ministra Anielle Franco Por Vinícius Lisboa, Agência Brasil A ministra da Igualdade Racial, Anielle Franco, adiantou nesta quinta-feira (16) que o
Estudo publicado na revista Nature mostra que o revumenib eliminou completamente o câncer de pacientes com leucemia mielogênica aguda (LMA) Por Bethânia Nunes, Metrópeles Um